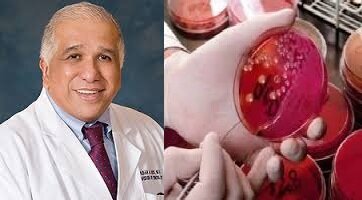
Patente de vacuna contra el Sida

Ciencia, Desarrollo y Sociedad en el Marco de la Conmemoración del Bicentenario de la Independencia de Panamá de España
By shel25
-
El científico y médico panameño Adán Ríos es reconocido por su aporte a la ciencia. Lleva treinta años dedicando su vida a conseguir una vacuna eficaz contra el sida. El oncólogo Adán Ríos, ha logrado nada menos que una de las tres patentes desarrolladas para vacunas preventivas contra el VIH en Estados Unidos.
-
 El científico panameño Guillermo Ameer, ha desarrollado en conjunto con su equipo de trabajo, en un laboratorio de la Universidad de Nortwestern, un nuevo método de vendaje, que se podría tomar como una curita líquida.
El científico panameño Guillermo Ameer, ha desarrollado en conjunto con su equipo de trabajo, en un laboratorio de la Universidad de Nortwestern, un nuevo método de vendaje, que se podría tomar como una curita líquida. -
 Dafni Mora, ingeniera mecánica, docente e investigadora científica en el área de energía y ambiente, dirigió un proyecto de investigación sobre soluciones energéticas de bajo consumo en edificaciones.
Dafni Mora, ingeniera mecánica, docente e investigadora científica en el área de energía y ambiente, dirigió un proyecto de investigación sobre soluciones energéticas de bajo consumo en edificaciones.
Se pretende hacer evaluaciones de técnicas pasivas y de bajo consumo locales, para medir el rendimiento energético en estas construcciones mediante herramientas de simulación. La intención es tantear soluciones para el más bajo consumo de energía eléctrica posible en edificaciones. -
 Esta iniciativa respaldada por SENACYT, impulsó el diseño y fabricación local de ventiladores mecánicos de emergencia, finalizó con dos prototipos validados en pruebas preclínicas, que están en espera de aprobación clínica en humanos. Dos prototipos superaron las pruebas funcionales con maniquíes de simulación médica y con animales vivos. El grupo PSED-AMBU-PLC creó un ventilador que funciona con una bolsa resucitadora (AMBU bag)y el grupo UTP-100P-FC construyó un ventilador de flujo continuo.
Esta iniciativa respaldada por SENACYT, impulsó el diseño y fabricación local de ventiladores mecánicos de emergencia, finalizó con dos prototipos validados en pruebas preclínicas, que están en espera de aprobación clínica en humanos. Dos prototipos superaron las pruebas funcionales con maniquíes de simulación médica y con animales vivos. El grupo PSED-AMBU-PLC creó un ventilador que funciona con una bolsa resucitadora (AMBU bag)y el grupo UTP-100P-FC construyó un ventilador de flujo continuo. -
 En abril de 2020, apenas transcurrido un mes haberse detectado el primer caso de covid-19 en Panamá, científicos del Instituto Gorgas lograron aislar varias cepas de la covid-19, siendo la primera etapa para realizar experimentos en la búsqueda de medicamentos antivirales y generar más secuencias de genomas completos.
En abril de 2020, apenas transcurrido un mes haberse detectado el primer caso de covid-19 en Panamá, científicos del Instituto Gorgas lograron aislar varias cepas de la covid-19, siendo la primera etapa para realizar experimentos en la búsqueda de medicamentos antivirales y generar más secuencias de genomas completos.
Want to make a timeline like this?
Use Timetoast to turn dates, events, milestones, and phases into a clear visual timeline you can build and share. Timetoast is a timeline maker for work, school, research, and stories.